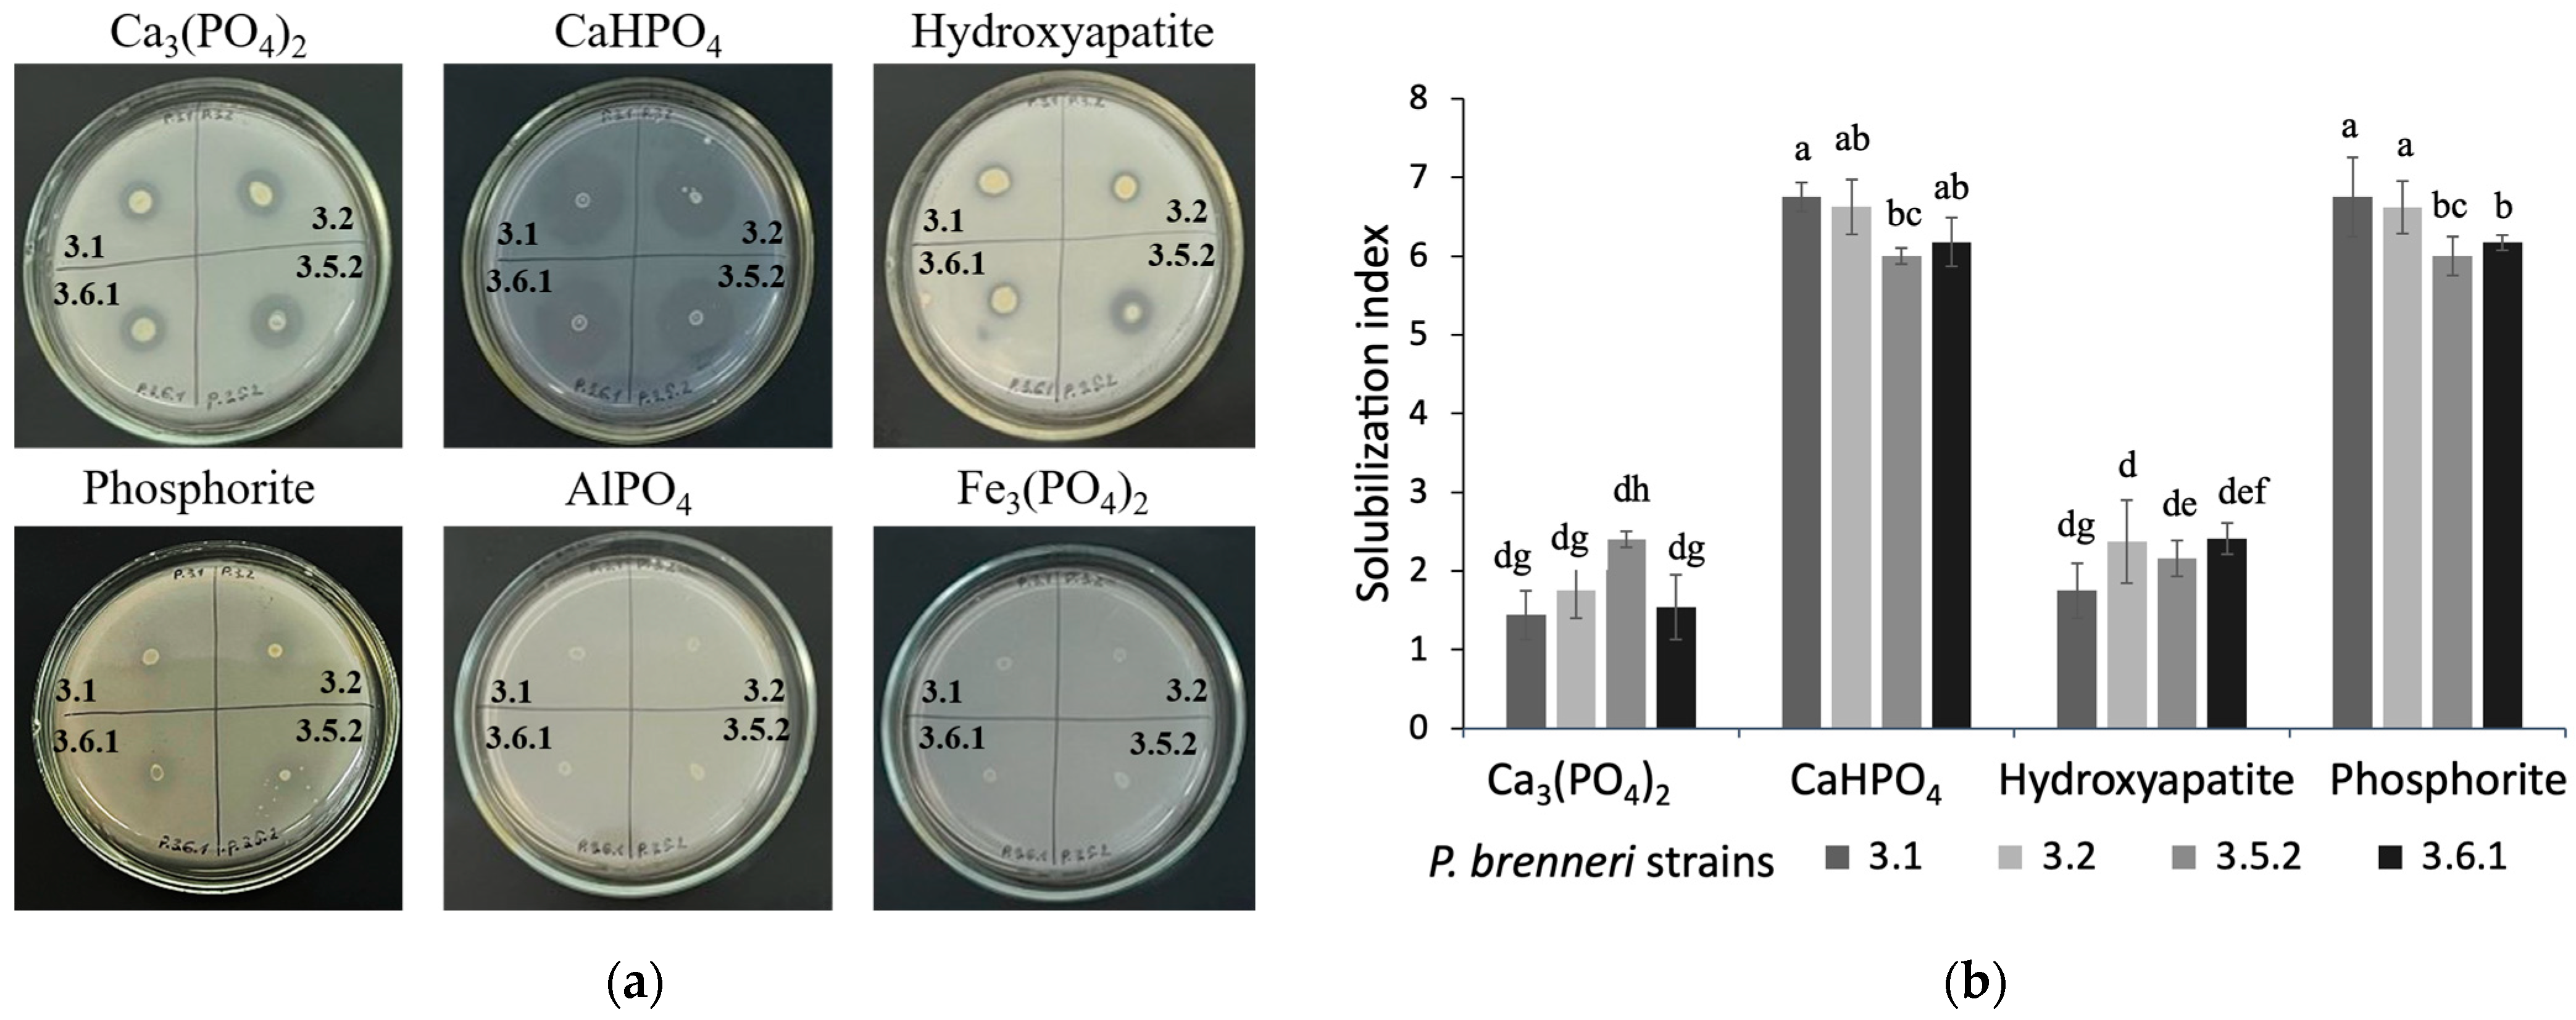
Microorganisms 11 01136 g001 Microorganisms 11 01136 g001

Phosphate Solubilization and Plant Growth Promotion by Pantoea brenneri Soil Isolates
Abstract
1. Introduction
2. Materials and Methods
2.1. Bacterial Strains and Culture Media
2.2. Determination of the P-Solubilization Ability of Bacteria
2.3. Optimization of Culture Conditions and Media Composition for P-Solubilization
2.4. Determination of Produced Organic Acids
2.5. Alkaline and Acidic Phosphatase Activity Detection
2.6. Genomic Screening for the Genes Involved in Phosphate Metabolism
2.7. Seed Germination Assay
2.8. Greenhouse Experiments
2.9. Statistical Analysis
3. Results
3.1. P-Solubilizing Ability of P. brenneri Strains on Different Insoluble Phosphorus Sources
3.1.1. Phosphate Solubilization Ability on Solid Media
3.1.2. Phosphate Solubilization Efficiency on Liquid Media
3.2. Optimization of Culture Conditions and Media Composition for P-Solubilization
3.3. Determination of Produced Organic Acids by HPLC
3.4. Alkaline and Acidic Phosphatase Activity of P. brenneri Strains
3.5. Genes Involved in Phosphate Metabolism of P. brenneri
3.6. Effect of P. brenneri on Wheat Seed Germination
3.7. Inoculation Effects on Potato Traits in Greenhouse Experiments
4. Discussion
5. Conclusions
Supplementary Materials
Author Contributions
Funding
Data Availability Statement
Acknowledgments
Conflicts of Interest
References
- Gaigbe, T.V.; Bassarsk, L.; Gu, D.; Spoorenberg, T.; Zeifman, L. World Population Prospects 2022: Summary of Results; Department of Economic and Social Affairs, United Nations: New York, NY, USA, 2022. [Google Scholar]
- Alori, E.T.; Glick, B.R.; Babalola, O.O. Microbial Phosphorus Solubilization and Its Potential for Use in Sustainable Agriculture. Front. Microbiol. 2017, 8, 971. [Google Scholar] [CrossRef] [PubMed]
- Schachtman, D.P.; Reid, R.J.; Ayling, S.M. Phosphorus Uptake by Plants: From Soil to Cell. Plant Physiol. 1998, 116, 447–453. [Google Scholar] [CrossRef] [PubMed]
- Sanders, J.L.; Murphy, L.S.; Noble, A.; Melgar, R.; Perkins, J. Improving Phosphorus Use Efficiency with Polymer Technology. Procedia Eng. 2012, 46, 178–184. [Google Scholar] [CrossRef]
- Backer, R.; Rokem, J.S.; Ilangumaran, G.; Lamont, J.; Praslickova, D.; Ricci, E.; Subramanian, S.; Smith, D.L. Plant Growth-Promotion Rhizobacteria: Contex, Mechanisms of Action, and Roadmap to Commercialization of Biostimulants for Sustainable Agriculture. Front. Plant Sci. 2018, 9, 1473. [Google Scholar] [CrossRef] [PubMed]
- Lugtenberg, B.; Kamilova, F. Plant-Growth-Promotion Rhizobacteria. Annu. Rev. Microbiol. 2009, 63, 541–556. [Google Scholar] [CrossRef]
- Vacheron, J.; Desbrosses, G.; Bouffaud, M.L.; Touraine, B.; Moënne-Loccoz, Y.; Muller, D.; Legendre, L.; Wisniewski-Dye, F.; Progent-Combaret, C. Plant Growth-Promotion Rhizobacteria and Root System Functioning. Front. Plant Sci. 2013, 4, 356. [Google Scholar] [CrossRef] [PubMed]
- Ducousso-Detrez, A.; Fontaine, J.; Sahraoui, A.L.; Hijri, M. Diversity of Phosphate Chemical Forms in Soils and Their Contributions on Soil Microbial Community Structure Changes. Microorganisms. 2022, 10, 609. [Google Scholar] [CrossRef] [PubMed]
- Mwende Muindi, E. Understanding Soil Phosphorus. Int. J. Plant Soil Sci. 2019, 31, 1–18. [Google Scholar] [CrossRef]
- Liu, X.; Han, R.; Cao, Y.; Turner, B.L.; Ma, L.Q. Enhancing Phytate Availability in Soils and Phytate-P Acquisition by Plants: A Review. Environ. Sci. Technol. 2022, 56, 9196–9219. [Google Scholar] [CrossRef]
- Rizwanuddin, S.; Kumar, V.; Singh, P.; Naik, B.; Mishra, S.; Chauhan, M.; Saris, P.E.J.; Verma, A.; Kumar, V. Insight into Phytase-Producing Microorganisms for Phytate Solubilization and Soil Sustainability. Front. Microbiol. 2023, 14, 1127249. [Google Scholar] [CrossRef]
- Ghorbani Nasrabadi, R.; Greiner, R.; Menezes-Blackburn, D.; Meyermibach, E. Phosphate Solubilizing and Phytate Degrading Streptomyces Isolates Stimulate the Growth and P Accumulation of Maize (Zea ays) Fertilized with Different Phosphorus Sources. Geomicrobiology 2023, 40, 1–12. [Google Scholar] [CrossRef]
- Malboobi, M.A.; Owlia, P.; Behbahani, M.; Sarokhani, E.; Moradi, S.; Yakhchali, B.; Deljou, A.; Heravi, K.M. Solubilization of Organic and Inorganic Phosphates by Three Highly Efficient Soil Bacterial Isolates. World J. Microbiol. Biotechnol. 2009, 25, 1471–1477. [Google Scholar] [CrossRef]
- Li, B.; Wang, B.; Pan, P.; Li, P.; Qi, Z.; Zhang, Q.; Shi, C.; Hao, W.; Zhou, B.; Lin, R. Bacillus altitudinis Strain AMCC 101304: A Novel Potential Biocontrol Agent for Potato Common Scab. Biocontrol Sci. Technol. 2019, 29, 1009–1022. [Google Scholar] [CrossRef]
- Suleimanova, A.D.; Beinhauer, A.; Valeeva, L.R.; Chastukhina, I.B.; Balaban, N.P.; Shakirov, E.V.; Greiner, R.; Sharipova, M.R. Novel Glucose-1-Phosphatase with High Phytase Activity and Unusual Metal Ion Activation from Soil Bacterium Pantoea sp. Strain 3.5.1. Appl. Environ. Microbiol. 2015, 81, 6790–6799. [Google Scholar] [CrossRef]
- Suleimanova, A.D.; Itkina, D.L.; Pudova, D.S.; Sharipova, M.R. Identification of Pantoea Phytate-Hydrolyzing Rhizobacteria Based on Their Phenotypic Features and Multilocus Sequence Analysis (MLSA). Microbiology 2021, 90, 87–95. [Google Scholar] [CrossRef]
- Itkina, D.L.; Suleimanova, A.D.; Sharipova, M.R. Pantoea brenneri AS3 and Bacillus ginsengihumi M2.11 as Potential Biocontrol and Plant Growth-Promoting Agents. Microbiology 2021, 90, 210–218. [Google Scholar] [CrossRef]
- Xiao, C.Q.; Chi, R.A.; Huang, X.H.; Zhang, W.X.; Qiu, G.Z.; Wang, D.Z. Optimization for Rock Phosphate Solubilization by Phosphate-Solubilizing Fungi Isolated from Phosphate Mines. Ecol. Eng. 2008, 33, 187–193. [Google Scholar] [CrossRef]
- Kirui, C.K.; Njeru, E.M.; Runo, S. Diversity and Phosphate Solubilization Efficiency of Phosphate Solubilizing Bacteria Isolated from Semi-Arid Agroecosystems of Eastern Kenya. Microbiol. Insights 2022, 15, 11786361221088991. [Google Scholar] [CrossRef]
- Greiner, R.; Konietzny, U.; Jany, K.D. Purification and Characterization of Two Phytases from Escherichia coli. Arch. Biochem. Biophys. 1993, 303, 107–113. [Google Scholar] [CrossRef]
- Li, L.; Chen, R.; Zuo, Z.; Lv, Z.; Yang, Z.; Mao, W.; Liu, Y.; Zhou, Y.; Huang, J.; Song, Z. Evaluation and Improvement of Phosphate Solubilization by an Isolated Bacterium Pantoea agglomerans ZB. World J. Microbiol. Biotechnol. 2020, 36, 27. [Google Scholar] [CrossRef] [PubMed]
- Magallon-Servín, P.; Antoun, H.; Taktek, S.; Bashan, Y.; De-Bashan, L. The Maize Mycorrhizosphere as a Source for Isolation of Arbuscular Mycorrhizae-Compatible Phosphate Rock-Solubilizing Bacteria. Plant Soil. 2020, 451, 169–186. [Google Scholar] [CrossRef]
- Tabatabai, M.A.; Bremner, J.M. Use of p-nitrophenyl Phosphate for Assay of Soil Phosphatase Activity. Soil Biol. Biochem. 1969, 1, 301–307. [Google Scholar] [CrossRef]
- Fiodor, A.; Ajijah, N.; Dziewit, L.; Pranaw, K. Biopriming of Seed with Plant Growth-Promoting Bacteria for Improved Germination and Seedling Growth. Front. Microbiol. 2023, 14, 142966. [Google Scholar] [CrossRef]
- Steel, R.G.D.; Torrie, J.H.; Dicky, D.A. Principles and Procedures of Statistics: A Biometrical Approach, 3rd ed.; McGraw-Hill: New York, NY, USA, 1997; 666p. [Google Scholar]
- Chan, B.K.C. Data Analysis Using R Programming. Adv. Exp. Med. Biol. 2018, 1082, 47–122. [Google Scholar] [CrossRef] [PubMed]
- Sokolnikova, L.V.; Bulmakova, D.S.; Nevzorova, J.V.; Suleimanova, A.D. Role of Phosphatase Enzymes in Soil Phosphorus Mobilization by Pantoea brenneri strains. Biomics 2022, 14, 209–219. [Google Scholar] [CrossRef]
- Silva, L.I.D.; Pereira, M.C.; Mundstock, A.; Carvalho, X.D.; Buttros, V.H.T.; Pasqual, M.; Doria, J. Phosphorus-Solubilizing Microorganisms: A Key to Sustainable Agriculture. Agriculture 2023, 13, 462. [Google Scholar] [CrossRef]
- Ibáñez, A.; Diez-Galán, A.; Cobos, R.; Calvo-Peña, C.; Barreiro, C.; Medina-Turienzo, J.; Sánchez-García, M.; Coque, J.J.R. Using Rhizosphere Phosphate Solubilizing Bacteria to Improve Barley (Hordeum vulgare) Plant Productivity. Microorganisms. 2021, 9, 1619. [Google Scholar] [CrossRef]
- Zaballa, J.I.; Golluscio, R.; Ribaudo, C.M. Effect of the Phosphorus-Solubilizing Bacterium Enterobacter ludwigii on Barley Growth Promotion. Am. Sci. Res. J. Eng. Technol. 2020, 63, 144–157. [Google Scholar]
- Chen, Q.; Liu, S. Identification and Characterization of the Phosphate-Solubilizing Bacterium Pantoea sp. S32 in Reclamation Soil in Shanxi, China. Front. Microbiol. 2019, 10, 2171. [Google Scholar] [CrossRef]
- Walpola, B.C.; Kong, W.-S.; Yoon, M.-H. Solubilization of Inorganic Phosphates and Plant Growth Promotion by Pantoea Strains. Korean J. Soil Sci. Fert. 2013, 46, 494–501. [Google Scholar] [CrossRef]
- Olanrewaju, O.S.; Glick, B.R.; Babalola, O.O. Mechanisms of Action of Plant Growth Promoting Bacteria. World J. Microbiol. Biotechnol. 2017, 33, 197. [Google Scholar] [CrossRef] [PubMed]
- Thompson, K.A.; Summers, R.S.; Cook, S.M. Development and Experimental Validation of the Composition and Treatability of a New Synthetic Bathroom Greywater (SynGrey). Environ. Sci. (Camb.) 2017, 6, 1120–1131. [Google Scholar] [CrossRef]
- Singh, J.S.; Gupta, V.K. Soil Microbial Biomass: A Key Soil Driver in Management of Ecosystem Functioning. Sci. Total Environ. 2018, 634, 497–500. [Google Scholar] [CrossRef] [PubMed]
- Timofeeva, A.M.; Galyamova, M.; Sedykh, S. Prospects for Using Phosphate-Solubilizing Microorganisms as Natural Fertilizers in Agriculture. Plants 2022, 11, 2119. [Google Scholar] [CrossRef] [PubMed]
- Marra, L.M.; de Oliveira-Longatti, S.M.; Soares, C.R.F.S.; Olivares, F.L.; Moreira, F.M.D.S. The Amount of Phosphate Solubilization Depends on the Strain, C-Source, Organic Acids and Type of Phosphate. Geomicrobiol. J. 2019, 36, 232–242. [Google Scholar] [CrossRef]
- Saadouli, I.; Mosbah, A.; Ferjani, R.; Stathopoulou, P.; Galiatsatos, I.; Asimakis, E.; Marasco, R.; Daffonchio, D.; Tsiamis, G.; Ouzari, H.-I. The Impact of the Inoculation of Phosphate-Solubilizing Bacteria Pantoea agglomerans on Phosphorus Availability and Bacterial Community Dynamics of a Semi-Arid Soil. Microorganisms 2021, 9, 1661. [Google Scholar] [CrossRef]
- Tahir, M.; Naeem, M.A.; Shahid, M.; Khalid, U.; Farooq, A.U.; Ahmad, N.; Waqar, A. Inoculation of pqqE Gene Inhabiting Pantoea and Pseudomonas Strains Improves the Growth and Grain Yield of Wheat with a Reduced Amount of Chemical Fertilizer. J. Appl. Microbiol. 2020, 129, 575–589. [Google Scholar] [CrossRef]
- Lorenzi, A.S.; Bonatelli, M.L.; Chia, M.A.; Peressim, L.; Quecine, M.C. Opposite Sides of Pantoea agglomerans and Its Associated Commercial Outlook. Microorganisms 2022, 10, 2072. [Google Scholar] [CrossRef]
- Nannipieri, P.; Giagnoni, L.; Landi, L.; Renella, G. Role of Phosphatase Enzymes in Soil. In Phosphorus in Action, 1st ed.; Bünemann, E., Oberson, A., Frossard, E., Eds.; Soil Biology Springer: Berlin/Heidelberg, Germany, 2011; Volume 26, pp. 215–243. [Google Scholar] [CrossRef]
- Kalayu, G. Phosphate Solubilizing Microorganisms: Promising Approach as Biofertilizers. Int. J. Agron. 2019, 2019, 4917256. [Google Scholar] [CrossRef]
- Rawat, P.; Das, S.; Shankhdhar, D.; Shankhdhar, S.C. Phosphate-solubilizing Microorganisms: Mechanism and Their Role in Phosphate Solubilization and Uptake. J. Soil Sci. Plant Nutr. 2021, 21, 49–68. [Google Scholar] [CrossRef]
- Zangelmi, E.; Stankovic, T.; Malatesta, M.; Acquotti, D.; Pallitsch, K.; Peracchi, A. Discovery of a New, Recurrent Enzyme in Bacterial Phosphonate Degradation: (R)-1-Hydroxy-2-aminoethylphosphonate Ammonia-lyase. Biochemistry 2021, 60, 1214–1225. [Google Scholar] [CrossRef] [PubMed]
- Kumar, P.; Rani, S.; Dahiya, P.; Kumar, A.; Dang, A.S.; Suneja, P. Whole Genome Analysis for Plant Growth Promotion Profiling of Pantoea agglomerans CPHN2, a Non-rhizobial Nodule Endophyte. Front. Microbiol. 2022, 13, 998821. [Google Scholar] [CrossRef] [PubMed]
- Silva, U.C.; Cuadros-Orellana, S.; Silva, D.R.C.; Freitas-Junior, L.F.; Fernandes, A.C.; Leite, L.R.; Oliveira, C.A.; Santos, V.L.D. Genomic and Phenotypic Insights into the Potential of Rock Phosphate Solubilizing Bacteria to Promote Millet Growth in vivo. Front. Microbiol. 2021, 11, 574550. [Google Scholar] [CrossRef] [PubMed]
- Çalışkan, M.E.; Yousaf, F.; Yavuz, C.; Zia, M.A.B.; Çalışkan, S. History, production, current trends, and future prospects. In Potato Production Worldwide; Çalişkan, M.E., Bakhsh, A., Jabran, K., Eds.; Academic Press: Cambridge, MA, USA, 2023; pp. 1–18. [Google Scholar] [CrossRef]

| Strain | P-Source | Organic Acids (mM) | |||||||
|---|---|---|---|---|---|---|---|---|---|
| Oxalic | Malic | Formic | Malonic | Lactic | Maleic | Acetic | Citric | ||
| P. brenneri 3.2 | Hydroxyapatite | - | 1.02 ± 0.3 | 6.22 ± 1.5 | 1.73 ± 0.7 | - | 0.03 ± 0.2 | - | - |
| Phosphorite | - | 7.56 ± 0.4 | 7.24 ± 3.3 | - | 0.59 ± 0.27 | 0.02 ± 0.001 | 0.59 ± 0.17 | 0.16 ± 0.04 | |
| Tricalcium phosphate | - | 12.78 ± 1.01 | 11.3 ± 3.66 | - | 1.37 ± 0.4 | 0.02 ± 0.001 | 0.95 ± 0.3 | 0.15 ± 0.04 | |
| P. brenneri 3.5.2 | Hydroxyapatite | 1.95 ± 0.25 | 13.76 ± 1.17 | 8.7 ± 3.2 | 0.47 ± 0.05 | 2.06 ± 0.96 | - | 0.75 ± 0.27 | 0.13 ± 0.04 |
| Phosphorite | 0.46 ± 0.07 | 9.6 ± 0.66 | 7.54 ± 2.00 | - | 1.62 ± 0.3 | 0.03 ± 0.003 | 1.00 ± 0.03 | 0.17 ± 0.03 | |
| Tricalcium phosphate | - | 11.54 ± 0.82 | 10.11 ± 2.9 | 0.28 ± 0.02 | 1.35 ± 0.1 | 0.03 ± 0.001 | 0.5 ± 0.07 | 0.16 ± 0.03 | |
| Locus Tag | Gene | Product | Pathway |
|---|---|---|---|
| KKD31040 KKD31973 | gcd | quinoprotein glucose dehydrogenase | Gluconate production |
| KKD33374 | pqqB | pyrroloquinoline quinone biosynthesis protein PqqB | |
| KKD33373 | pqqC | pyrroloquinoline quinone biosynthesis protein PqqC | |
| KKD33372 | pqqD | pyrroloquinoline quinone biosynthesis peptide chaperone PqqD | |
| KKD33371 | pqqE | pyrroloquinoline quinone biosynthesis protein PqqE | |
| KKD33370 | pqqF | pyrroloquinoline quinone biosynthesis protein PqqF | |
| KKD32511 | ppx | Exopolyphosphatase | Degradation of inorganic polyphosphates |
| KKD32512 | ppk | Polyphosphate kinase | |
| KKD31812 | ppa | Inorganic pyrophosphatase | |
| KKD34216 | psiF | Phosphate starvation-inducible protein PsiF | |
| KKD31910 | psiE | Phosphate starvation-inducible protein PsiE | |
| KKD34188 KKD30886 | phyK | 3-phytase | Organic phosphates mineralization |
| KKD33729 | agpP | glucose-1-phosphatase AgpP | |
| KKD32984 | phoA | alkaline phosphatase | |
| KKD30737 | pstS | phosphate transport system substrate-binding protein | Phosphate transport |
| KKD30736 | pstC | phosphate transport system permease subunit PstC | |
| KKD30735 | pstA | phosphate transport system permease subunit PstA | |
| KKD30734 | pstB | phosphate transport system ATP-binding protein | |
| KKD32884 | phnF | phosphonate metabolism transcriptional regulator | Degradation of phosphonates |
| KKD32885 | phnG | phosphonate C-P lyase system protein | |
| KKD32887 | phnI | carbon-phosphorus lyase complex subunit PhnI | |
| KKD32888 | phnJ | carbon-phosphorus lyase complex subunit PhnJ | |
| KKD32889 | phnK | phosphonate C-P lyase system protein | |
| KKD32890 | phnL | phosphonate C-P lyase system protein | |
| KKD32891 | phnM | phosphonate metabolism protein PhnM | |
| KKD32892 | phnN | ribose 1,5-bisphosphate phosphokinase PhnN | |
| KKD32894 | phnC | phosphonate transport system ATP-binding protein | |
| KKD32895 | phnD | phosphonate transport system substrate-binding protein | |
| KKD3289 | phnE | phosphonate ABC transporter permease |
Disclaimer/Publisher’s Note: The statements, opinions and data contained in all publications are solely those of the individual author(s) and contributor(s) and not of MDPI and/or the editor(s). MDPI and/or the editor(s) disclaim responsibility for any injury to people or property resulting from any ideas, methods, instructions or products referred to in the content. |
© 2023 by the authors. Licensee MDPI, Basel, Switzerland. This article is an open access article distributed under the terms and conditions of the Creative Commons Attribution (CC BY) license (https://creativecommons.org/licenses/by/4.0/).
Share and Cite
Suleimanova, A.; Bulmakova, D.; Sokolnikova, L.; Egorova, E.; Itkina, D.; Kuzminova, O.; Gizatullina, A.; Sharipova, M. Phosphate Solubilization and Plant Growth Promotion by Pantoea brenneri Soil Isolates. Microorganisms 2023, 11, 1136. https://doi.org/10.3390/microorganisms11051136
Suleimanova A, Bulmakova D, Sokolnikova L, Egorova E, Itkina D, Kuzminova O, Gizatullina A, Sharipova M. Phosphate Solubilization and Plant Growth Promotion by Pantoea brenneri Soil Isolates. Microorganisms. 2023; 11(5):1136. https://doi.org/10.3390/microorganisms11051136
Chicago/Turabian StyleSuleimanova, Aliya, Daria Bulmakova, Lidiya Sokolnikova, Evgenia Egorova, Daria Itkina, Olga Kuzminova, Albina Gizatullina, and Margarita Sharipova. 2023. "Phosphate Solubilization and Plant Growth Promotion by Pantoea brenneri Soil Isolates" Microorganisms 11, no. 5: 1136. https://doi.org/10.3390/microorganisms11051136
APA StyleSuleimanova, A., Bulmakova, D., Sokolnikova, L., Egorova, E., Itkina, D., Kuzminova, O., Gizatullina, A., & Sharipova, M. (2023). Phosphate Solubilization and Plant Growth Promotion by Pantoea brenneri Soil Isolates. Microorganisms, 11(5), 1136. https://doi.org/10.3390/microorganisms11051136

